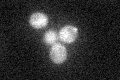
YDL234C
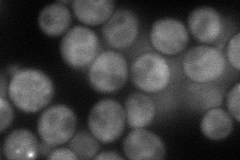
YDL234C
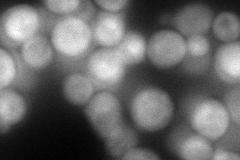
YDL234C
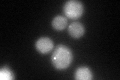
YDL234C
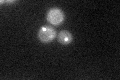
YDL234C

View description
GTPase-activating protein for yeast Rab family members including: Ypt7p (most effective), Ypt1p, Ypt31p, and Ypt32p (in vitro); involved in vesicle mediated protein trafficking
Localization:
Intensity:
Fold change:
Significance:
-
C’ GFP library in SD
punctate:cytosol29.53 -
N' NOP1pr-GFP in SD
cytosol,punctate75.2908 -
N' TEF2pr-mCherry in SD
cytosol,punctate144.575 -
N' NATIVEpr-GFP in SD

punctate29.0503 -
N' TEF2pr-VC and Cyto-VN in SD

cytosol46.9811 -
C’ GFP library in SD+DTT
punctate.cytosol61.852.09Yes -
C’ GFP library in SD+H2O2
punctate.cytosol31.851.07No -
C’ GFP library in Starvation Media

punctateN/AN/AYes -
C’ GFP library on the background of Pup2-DaMP

punctate:cytosol -
C’ GFP library on the background of CCT mutant

punctate:cytosol34.32911.16221No
